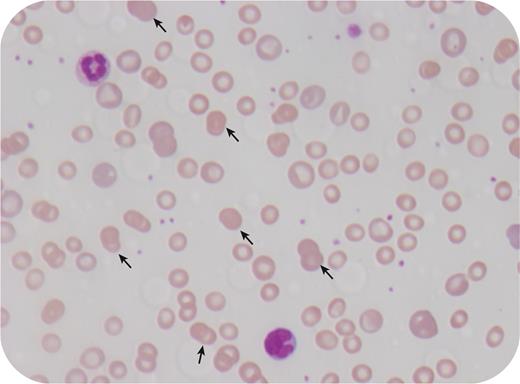
graphic

An 8-year-old girl with prior respiratory syncytial virus infection presented to the emergency department with lethargy, weakness, pallor, and yellow discoloration of the eyes. Examination revealed pallor, jaundice, and splenomegaly. Laboratory investigations revealed hemoglobin 4.0 g/dL, white cell count 14 000/μL, neutrophils 11 200/μL, platelet count 418 000/μL, mean corpuscular volume 103 fL, reticulocyte count 19.7%, total bilirubin 3.9 mg/dL, unconjugated bilirubin 3.7 mg/dL, lactate dehydrogenase 660 units/L, and haptoglobin <0.01 mg/dL. The fibrinogen was mildly increased at 4.4 g/dL. Direct Coombs test was positive for immunoglobulin G. The blood smear showed that 10% of red cells were doublet spherocytes (arrows; 40× lens objective). Strikingly, single spherocytes were absent. The diagnosis was postinfectious warm antibody autoimmune hemolytic anemia, which was treated with red cell transfusion and prednisolone, after which her anemia resolved, mean corpuscular volume normalized, and doublet spherocytes disappeared from the blood smear.
Doublet spherocytes have only been rarely reported in autoimmune hemolytic anemia. The cause for doublet formation is not clear but it may be postulated that it is related to a change in the rheological properties of the red cell after antibody binding and/or a change in the concentration of plasma proteins (eg, increased fibrinogen). In normal smears, doublet spherocytes comprise <1% of red cells. In occasional cases, doublet spherocytes may be the prominent feature in autoimmune hemolytic anemia, with individual spherocytes being rare or absent.
For additional images, visit the ASH Image Bank, a reference and teaching tool that is continually updated with new atlas and case study images. For more information, visit https://imagebank.hematology.org.

This feature is available to Subscribers Only
Sign In or Create an Account Close Modal